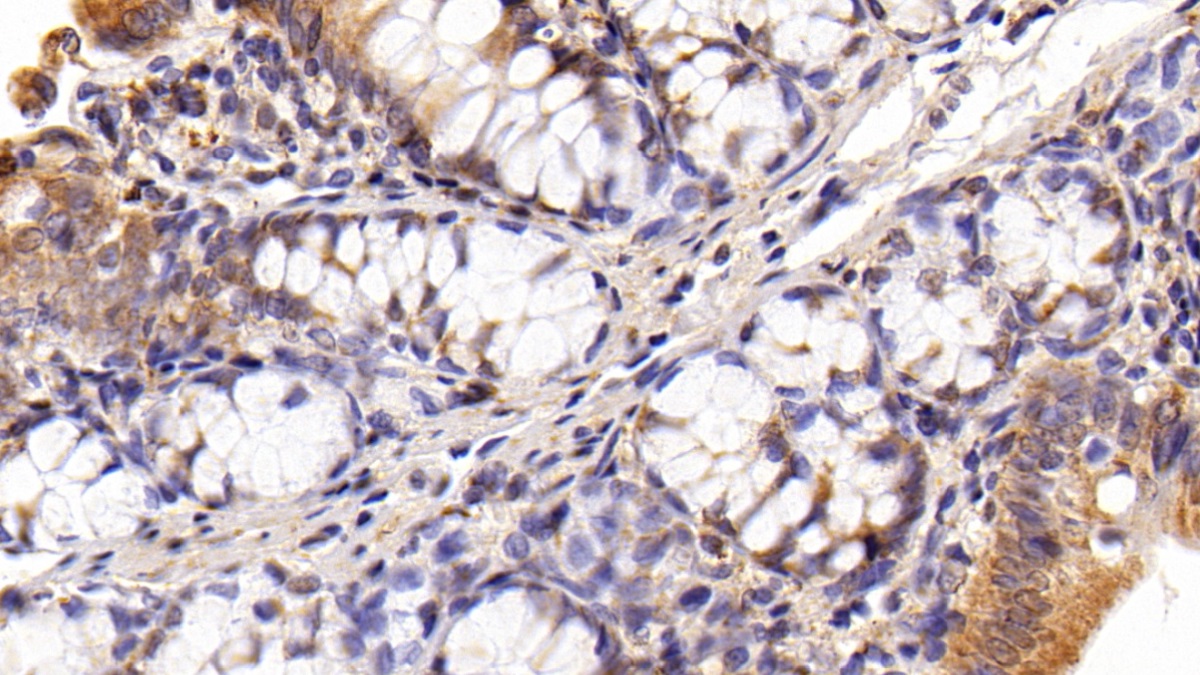

- KO-Validated
Polyclonal Antibody to High Mobility Group Protein 1 (HMGB1)
HMG1; HMG3; SBP1; Sulfoglucuronyl Carbohydrate Binding Protein; Amphoterin; High Mobility Group Box 1 Protein
- Product No.PAA399Ra01
- Organism SpeciesRattus norvegicus (Rat) Same name, Different species.
- SourcePolyclonal antibody preparation
- HostRabbit
- Potencyn/a
- Ig Type IgG
- PurificationAntigen-specific affinity chromatography followed by Protein A affinity chromatography
- LabelNone
- Immunogen RPA399Ra01-Recombinant High Mobility Group Protein 1 (HMGB1)
- Buffer Formulation0.01M PBS, pH7.4, containing 0.05% Proclin-300, 50% glycerol.
- TraitsLiquid
- Concentration0.5mg/mL
- Organism Species MoreHomo sapiens (Human), Mus musculus (Mouse)
- ApplicationsWB; IHC
If the antibody is used in flow cytometry, please check FCM antibodies. - DownloadInstruction Manual
- UOM 20µl100µl 200µl 1ml 10ml
- FOB
US$ 103
US$ 239
US$ 342
US$ 855
US$ 3420
For more details, please contact local distributors!
SPECIFITY
The antibody is a rabbit polyclonal antibody raised against HMGB1. It has been selected for its ability to recognize HMGB1 in immunohistochemical staining and western blotting.
USAGE
Western blotting: 0.01-2µg/mL;
Immunohistochemistry: 5-20µg/mL;
Optimal working dilutions must be determined by end user.
STORAGE
Store at 4°C for frequent use. Stored at -20°C in a manual defrost freezer for two year without detectable loss of activity. Avoid repeated freeze-thaw cycles.
STABILITY
The thermal stability is described by the loss rate. The loss rate was determined by accelerated thermal degradation test, that is, incubate the protein at 37°C for 48h, and no obvious degradation and precipitation were observed. The loss rate is less than 5% within the expiration date under appropriate storage condition.
GIVEAWAYS
INCREMENT SERVICES
-
 Antibody Labeling Customized Service
Antibody Labeling Customized Service
-
 Protein A/G Purification Column
Protein A/G Purification Column
-
 Staining Solution for Cells and Tissue
Staining Solution for Cells and Tissue
-
 Positive Control for Antibody
Positive Control for Antibody
-
 Tissue/Sections Customized Service
Tissue/Sections Customized Service
-
 Phosphorylated Antibody Customized Service
Phosphorylated Antibody Customized Service
-
 Western Blot (WB) Experiment Service
Western Blot (WB) Experiment Service
-
 Immunohistochemistry (IHC) Experiment Service
Immunohistochemistry (IHC) Experiment Service
-
 Immunocytochemistry (ICC) Experiment Service
Immunocytochemistry (ICC) Experiment Service
-
 Flow Cytometry (FCM) Experiment Service
Flow Cytometry (FCM) Experiment Service
-
 Immunoprecipitation (IP) Experiment Service
Immunoprecipitation (IP) Experiment Service
-
 Immunofluorescence (IF) Experiment Service
Immunofluorescence (IF) Experiment Service
-
 Buffer
Buffer
-
 DAB Chromogen Kit
DAB Chromogen Kit
-
 SABC Kit
SABC Kit
-
 Long-arm Biotin Labeling Kit
Long-arm Biotin Labeling Kit
-
 Real Time PCR Experimental Service
Real Time PCR Experimental Service
| Magazine | Citations |
| Scandinavian Journal of Trauma, Resuscitation and Emergency Medicine | High mobility group box protein-1 (HMGB-1) as a new diagnostic marker in patients with acute appendicitis PubMed: PMC3094252 |
| Respiration | Protective Effect of Nicotine on Lipopolysaccharide-Induced Acute Lung Injury in Mice Karger: 000319151 |
| Surgery | Clinical relevance of single nucleotide polymorphisms of the high mobility group box 1 protein gene in patients with major trauma in Southwest China Pubmed: 22047946 |
| Viral Immunology | Is HMGB1 a New Indirect Marker for Revealing Fibrosis in Chronic Hepatitis and a New Therapeutic Target in Treatment? Wiley: source |
| Chinese Medical Journal | Severity of sepsis is correlated with the elevation of serum high-mobility group box 1 in rats CMJ: 2009218808935901080 |
| Microbiology and Immunology | Diagnostic value of serum concentrations of high-mobility group-box protein 1 and soluble hemoglobin scavenger receptor in brucellosis PubMed: 23278480 |
| ACTA biochimica polonica | High mobility group B1 levels in sepsis and disseminated intravascular coagulation Actabp: Source |
| Anesthesia and Analgesia | The Inhibitory Effect of Lidocaine on the Release of High Mobility Group Box 1 in Lipopolysaccharide-Stimulated Macrophages PubMed: 21288974 |
| Rheumatology International | Elevated serum levels of high mobility group box protein 1 (HMGB1) in patients with ankylosing spondylitis and its association with disease activity and quality of life PubMed: 23143556 |
| Inflammation Research | Mammalian target of rapamycin complex 2 regulates inflammatory response to stress PubMed: 22899279 |
| Acta Biochimica et Biophysica Sinica | IGF-1 alleviates ox-LDL-induced inflammation via reducing HMGB1 release in HAECs PubMed: 22782142 |
| LabVest | The suppression of TRIM21 and the accumulation of IFN-α play crucial roles in the pathogenesis of osteonecrosis of the femoral head. PubMed: 22825687 |
| Biomark Insights | Decreased Epidermal Growth Factor (EGF) Associated with HMGB1 and Increased Hyperactivity in Children with Autism PubMed: PMC3623607 |
| Evidence-based Complementary and Alternative Medicine | ATF3 Protects against LPS-Induced Inflammation in Mice via Inhibiting HMGB1 Expression PubMed: PMC3770047 |
| Exp Ther Med | Correlation between serum high-mobility group box-1 levels and high-sensitivity C-reactive protein and troponin I in patients with coronary artery disease Pubmed: 23935732 |
| International of Rheumatic disesases | Serum levels of high mobility group box 1 protein and its association with quality of life and psychological and functional status in patients with fibromyalgia Pubmed: 23901875 |
| Surgery | A novel serum marker for biliary tract cancer: Diagnostic and prognostic values of quantitative evaluation of serum mucin 5AC (MUC5AC) Pubmed: 24468034 |
| Acta Pharmacol Sin. | Simvastatin suppresses vascular inflammation and atherosclerosis in ApoE-/- mice by downregulating the HMGB1-RAGE axis Pubmed: 23564080 |
| BMC pulmonary medicine | Soluble receptor for advanced glycation end-products and progression of airway disease Pubmed: 24758342 |
| Biochemical Pharmacology | Ascorbic acid reduces HMGB1 secretion in lipopolysaccharide-activated RAW 264.7 cells and improves survival rate in septic mice by activation of Nrf2/HO-1 signals Pubmed:25896849 |
| BioMed Research International | Effects of Single or Combined Treatments with Radiation and Chemotherapy on Survival and Danger Signals Expression in Glioblastoma Cell Lines Hindawi:Source |
| J Cardiothorac Surg. | High plasma levels of high mobility group box 1 is associated with the risk of sepsis in severe blunt chest trauma patients: a prospective cohort study Pubmed:Pmc4132233 |
| J Leukoc Biol. | HMGB1 is an early and critical mediator in an animal model of uveitis induced by IRBP-specific T cells Pubmed:24374967 |
| PLOS ONE | The Alarmin Concept Applied to Human Renal Transplantation: Evidence for a Differential Implication of HMGB1 and IL-33 Pubmed:24586382 |
| Journal of Surgical Research | Plasma levels of high mobility group box 1 increase in patients with posttraumatic stress disorder after severe blunt chest trauma: a prospective cohort study Pubmed:25016440 |
| Virus Research | High-mobility group box-1, promising serological biomarker for the distinction of human WNV disease severity Pubmed:25197038 |
| Journal of Stroke and Cerebrovascular Diseases | Increased VEGF and Decreased SDF-1α in Patients with Silent Brain Infarction Are Associated with Better Prognosis after First-Ever Acute Lacunar Stroke Pubmed:25601176 |
| 中华临床医师杂志 | 高迁移率族蛋白B1和神经元烯醇化酶对心脏骤停大鼠复苏后脑损伤评价的研究 Journal: Fulltext |
| Oxidative Medicine and Cellular Longevity | Diabetes-Induced Oxidative Stress in Endothelial Progenitor Cells May Be Sustained by a Positive Feedback Loop Involving High Mobility Group Box-1 Journals: Omcl |
| Int Immunopharmacol | Hesperidin ameliorates lipopolysaccharide-induced acute lung injury in mice by inhibiting HMGB1 release PubMed: 25724384 |
| Journal of Immunotherapy | Wogonin Inhibits Tumor-derived Regulatory Molecules by Suppressing STAT3 Signaling to Promote Tumor Immunity PubMed: 25962106 |
| Atherosclerosis | Retinoic acid inhibits tissue factor and HMGB1 via modulation of AMPK activity in TNF-α activated endothelial cells and LPS-injected mice PubMed: 26116962 |
| PLOS ONE | Plasma HMGB-1 Levels in Subjects with Obesity and Type 2 Diabetes: A Cross-Sectional Study in China PubMed: 26317615 |
| Int Immunopharmacol | Betulin attenuates lung and liver injuries in sepsis PubMed: 26644168 |
| journal of cardiochoracic surgery | High mobility group box 1 gene polymorphism is associated with the risk of postoperative atrial fibrillation after coronary artery bypass surgery PubMed: 26109393 |
| Int Immunopharmacol | Glycyrrhizin reduces HMGB1 secretion in lipopolysaccharide-activated RAW 264.7 cells and endotoxemic mice by p38/Nrf2-dependent induction of HO-1 PubMed: 25812767 |
| World J Gastroenterol | Overexpression of HMGB1 A-box reduced lipopolysaccharide-induced intestinal inflammation via HMGB1/TLR4 signaling in vitro PubMed: 26167076 |
| Neurotoxicology | Allopurinol reduces severity of delayed neurologic sequelae in experimental carbon monoxide toxicity in rats PubMed: 25845300 |
| Journal of Neuroimmunology | HMGB1 expression patterns during the progression of experimental autoimmune encephalomyelitis PubMed: 25773152 |
| J Neuroinflammation | HMGB1 release triggered by the interaction of live retinal cells and uveitogenic T cells is Fas/FasL activation-dependent PubMed: 26394985 |
| PLoS One | Low Shear Stress Induced HMGB1 Translocation and Release via PECAM-1/PARP-1 Pathway to Induce Inflammation Response PubMed: 25793984 |
| Neuroscience | Interleukin-33 is released in spinal cord and suppresses experimental autoimmune encephalomyelitis in mice PubMed: 26363151 |
| Cancer Biomarkers | Serum levels of HMGB1 have a diagnostic role in metastatic renal cell cancer Pubmed:27062570 |
| International Immunopharmacology | Oxymatrine attenuates CCl 4-induced hepatic fibrosis via modulation of TLR4-dependent inflammatory and TGF-β1 signaling pathways Pubmed:27179304 |
| SpringerPlus | Ethyl pyruvate attenuated coxsackievirus B3-induced acute viral myocarditis by suppression ofHMGB1/RAGE/NF-ΚB pathway. Pubmed:27026909 |
| Acta Biochim Biophys Sin (Shanghai). | High mobility group box1 protein is involved in acute inflammation induced by Clostridium difficile toxin A. content:2016 |
| United States Patent Application | COMPOSITIONS AND METHODS FOR INHIBITING HMGB1 ACTIVATION OF MELANOCYTES y2016:0077082.html |
| United States Patent Application | METHOD OF MAKING A SKIN CARE COMPOSITION y2016:0077080.html |
| Oxid Med Cell Longev. | Oxidative Stress in Metabolic Disorders: Pathogenesis, Prevention, and Therapeutics Pubmed:26949450 |
| Oncotarget | Zoledronic acid-encapsulating self-assembling nanoparticles and doxorubicin: a combinatorial approach to overcome simultaneously chemoresistance and immunoresistance in breast tumors pubmed:26980746 |
| clinical biochemistry | Relevance of pre-analytical blood management on the emerging cardiovascular protein biomarkers TWEAK and HMGB1 and on miRNA serum and plasma profiling. pubmed:27847340 |
| disease markers | Serum HMGB1 as a Potential Biomarker for Patients with Asbestos-Related Diseases. pubmed:28348451 |
| Biogerontology. | Changes in pro-inflammatory markers and leucine concentrations in response to Nordic Walking training combined with vitamin D supplementation in elderly women. pubmed:28316011 |
| Journal of Immunology Research | Serum HMGB1 serves as a novel laboratory indicator reflecting disease activity and pubmed:27800496 |
| Springerplus | Ethyl pyruvate attenuated coxsackievirus B3-induced acute viral myocarditis by suppression of HMGB1/RAGE/NF-ΚB pathway pubmed:27026909 |
| Molecular Immunology | HMGB1 blockade differentially impacts pulmonary inflammation and defense responses in poly (I: C)/LPS-exposed heart transplant mice pubmed:27387278 |
| Oxidative Medicine and Cellular Longevity | Reduced HMGB 1-Mediated Pathway and Oxidative Stress in Resveratrol-Treated Diabetic Mice: A Possible Mechanism of Cardioprotection of Resveratrol in … pubmed:27833703 |
| BioMed Research International | High Mobility Group Box1 Protein Is Involved in Endoplasmic Reticulum Stress Induced by Clostridium difficile Toxin A pubmed:27579314 |
| Cardiology | The role of high mobility group box 1 protein in interleukin-18-induced myofibroblastic transition of valvular interstitial cells pubmed:27395056 |
| Innate immunity | HMGB1 exacerbates experimental mouse colitis by enhancing innate lymphoid cells 3 inflammatory responses via promoted IL-23 production pubmed:27670944 |
| Urolithiasis. | Urinary MCP-1、HMGB1 increased in calcium nephrolithiasis patients and the influence ofhypercalciuria on the production of the two cytokines. pubmed:27393275 |
| Journal of Investigative Surgery | Diagnostic Value of High-Mobility Group Box 1 (HMGB1) Protein in Acute and Perforated Appendicitis. pubmed:27922766 |
| J Cell Biochem | High Mobility Group Box 1 Mediates Interferon-r-Induced Phenotypic Modulation of Vascular Smooth Muscle Cells. pubmed:27579780 |
| BMC Vet Res. | Blood markers of fibrinolysis and endothelial activation in canine babesiosis. pubmed:28363279 |
| Immunol Res. | Glycyrrhizin ameliorates experimental colitis through attenuating interleukin-17-producing T cell responses via regulating antigen-presenting cells. pubmed:28108937 |
| Biomed Pharmacother. | SIRT1 inhibits releases of HMGB1 and HSP70 from human umbilical vein endothelial cells caused by IL-6 and the serum from a preeclampsia patient and protects the cells from death. pubmed:28122311 |
| Sci Rep. | Bone marrow-derived mesenchymal stem cells (BMSCs) repair acute necrotized pancreatitis by secreting microRNA-9 to target the NF-κB1/p50 gene in rats. pubmed:28373667 |
| Integrative Cancer Science and Therapeutics | The expression of HMGB1 and the receptor for advanced glycation end products (RAGE) in epithelial ovarian cancer pdf:ICST-4-232.pdf |
| Journal of Food and Drug Analysis | Anti-inflammatory effect of cinnamaldehyde and linalool from the leaf essential oil of Cinnamomum osmophloeum Kanehira in endotoxin-induced … S1021-9498(17)30081-9 |
| Biomedicine & Pharmacotherapy | SIRT1 inhibits releases of HMGB1 and HSP70 from human umbilical vein endothelial cells caused by IL-6 and the serum from a preeclampsia patient and protects the cells from death DOI:10.1016/j.biopha.2017.01.087 |
| Stem Cell Rev and Rep | Induction of Immunogenic Cell Death in Lymphoma Cells by Wharton’s Jelly Mesenchymal Stem Cell Conditioned Medium pubmed:28918474 |
| Scientific Reports COMMUNICATIONS | Mineral particles stimulate innate immunity through neutrophil extracellular traps containing HMGB1 pubmed:29192209 |
| Biochemical and Biophysical Research Communications | Oxidized low-density lipoprotein promotes osteoclast differentiation from CD68 positive mononuclear cells by regulating HMGB1 release pubmed:29146189 |
| Pulmonary Pharmacology & Therapeutics | HMGB1 promotes HLF-1 proliferation and ECM production through activating HIF1-a-regulated aerobic glycolysis pubmed:28571757 |
| Biomedical Research | Correlation between high mobility group box 1 protein, tumor necrosis factor-α, and acute coronary syndrome ISSN 0970-938X |
| Molecular Cancer | PERK induces resistance to cell death elicited by endoplasmic reticulum stress and chemotherapy pubmed:28499449 |
| BMC Complementary and Alternative Medicine | Assessing the recovery from prerenal and renal acute kidney injury after treatment with single herbal medicine via activity of the biomarkers HMGB1, NGAL and KIM-1 in kidney proximal tubular cells treated by cisplatin with different doses and exposure times. pubmed:29258482 |
| 25 | Blocking the Feedback Loop between Neuroendocrine Differentiation and Macrophages Improves the Therapeutic Effects of Enzalutamide (MDV3100) on Prostate Cancer. pubmed:29191973 |
| Nature microbiology | Secreted tryptophanyl-tRNA synthetase as a primary defence system against infection. pubmed:27748732 |
| Cellular physiology and biochemistry | Macrophage Inflammatory Protein-2 in High Mobility Group Box 1 Secretion of Macrophage Cells Exposed to Lipopolysaccharide. pubmed:28662496 |
| Molecular Medicine Reports | Niclosamide attenuates inflammatory cytokines via the autophagy pathway leading to improved outcomes in renal ischemia/reperfusion injury pubmed:28627643 |
| Cell Death & Disease | AMP-activated protein kinase agonist N 6-(3-hydroxyphenyl) adenosine protects against fulminant hepatitis by suppressing inflammation and apoptosis Articles:s41419-017-0118-0 |
| Journal of Molecular Cell Biology | S1 PR 3 is essential for phosphorylated fingolimod to protect astrocytes against oxygen‐glucose deprivation‐induced neuroinflammation via inhibiting TLR 2/4‐NF κB … Pubmed:29536648 |
| Frontiers in Immunology | Glycyrrhizin Protects Mice against Experimental Autoimmune Encephalomyelitis by Inhibiting HMGB1 Expression and Neuronal HMGB1 Release Pubmed:30013568 |
| Oncoimmunology | Bromodomain inhibition exerts its therapeutic potential in malignant pleural mesothelioma by promoting immunogenic cell death and changing the tumor immune … Pubmed:29399399 |
| Cancer Immunology, Immunotherapy | Tumor lysate-based vaccines: on the road to immunotherapy for gallbladder cancer Pubmed:29600445 |
| Cytokine | Porcine reproductive and respiratory syndrome virus induces concurrent elevation of High Mobility Group Box-1 protein and pro-inflammatory cytokines in … Pubmed:29895396 |
| Frontiers in Neurology | Ursolic Acid Ameliorates Inflammation in Cerebral Ischemia and Reperfusion Injury Possibly via High Mobility Group Box 1/Toll-Like Receptor 4/NFκB … Pubmed:29867706 |
| Biomedicine & Pharmacotherapy | Oridonin enhances the cytotoxicity of 5-FU in renal carcinoma cells by inducting necroptotic death Pubmed:29958141 |
| Inflammation Research | Luteolin activates ERK1/2- and Ca-dependent HO-1 induction that reduces LPS-induced HMGB1, iNOS/NO, and COX-2 expression in RAW264.7 cells and … Pubmed:29497773 |
| Journal of Food and Drug Analysis | Anti-inflammatory effect of cinnamaldehyde and linalool from the leaf essential oil of Cinnamomum osmophloeum Kanehira in endotoxin-induced mice Pubmed:29389558 |
| Biochemical and Biophysical Research Communications | Sirt1 S-nitrosylation induces acetylation of HMGB1 in LPS-activated RAW264. 7 cells and endotoxemic mice Pubmed:29680657 |
| Neurological Sciences | Thrombomodulin, alarmin signaling, and copeptin: cross-talk between obesity and acute ischemic stroke initiation and severity in Egyptians Pubmed:29637447 |
| International Journal of Gynecology & Obstetrics | Increased serum levels of high mobility group protein B1 and calprotectin in pre‐eclampsia Pubmed:29569400 |
| Advances in Experimental Medicine and Biology | Molecules of Damage-Associated Patterns in Bronchoalveolar Lavage Fluid and Serum in Chronic Obstructive Pulmonary Disease Pubmed:29429028 |
| Taiwanese Journal of Obstetrics & Gynecology | HMGB1-RAGE signaling pathway in pPROM Pubmed:29673663 |
| Chronic obstructive pulmonary disease (COPD)--from biomarkers to clinical phenotypes ISBN:978-951-51-4039-5 | |
| Journal of Pharmacological Sciences | Butyrate suppresses abnormal proliferation in colonic epithelial cells under diabetic state by targeting HMGB1 Doi: 10.1016/j.jphs.2018.07.012 |
| Biomaterials Science | Delivery of 5'-Triphosphate RNA with Endosomolytic Nanoparticles Potently Activates RIG-I to Improve Cancer Immunotherapy Doi: 10.1039/C8BM01064A |
| iris-AperTO | |
| Toxicological Sciences | Apoptosis resistance in fibroblasts precedes progressive scarring in pulmonary fibrosis and is partially mediated by Toll-like receptor 4 activation Pubmed: 31020321 |
| Molecular Medicine | FBXW7 suppresses HMGB1-mediated innate immune signaling to attenuate hepatic inflammation and insulin resistance in a mouse model of nonalcoholic … Pubmed: 31215394 |
| international immunopharmacology | Dulaglutide mitigates inflammatory response in fibroblast-like synoviocytes Pubmed: 31185450 |
| Food & Function | Network pharmacology oriented study reveals inflammatory state-dependent dietary supplement hepatotoxicity responses in normal and diseased rats Pubmed: 31140472 |
| International Immunopharmacology | BET bromodomain inhibitor JQ1 promotes immunogenic cell death in tongue squamous cell carcinoma Pubmed: 31600692 |
| Experimental and Therapeutic Medicine | High mobility group box protein 1 neutralization therapy in ovine bacteremia: Lessons learned from an ovine septic shock model incorporating intensive care support Pubmed: 31602200 |
| Oxidative Medicine and Cellular Longevity | Evaluation of the Effect Derived from Silybin with Vitamin D and Vitamin E Administration on Clinical, Metabolic, Endothelial Dysfunction, Oxidative Stress Parameters … Pubmed: 31737175 |
| Pathobiology | Magnetic hyperthermia using self-controlled heating elements consisting of Fe-Al milling alloy induces cancer cell apoptosis while preserving skeletal muscle Pubmed: 31722347 |
| Canadian Journal of Physiology and Pharmacology | Suppression of high-mobility group box 1 ameliorates xerostomia in a sjogren syndrome-triggered mouse model Pubmed: 31935120 |
| Neurotoxicity Research | HMGB1 Mediates Paraquat-Induced Neuroinflammatory Responses via Activating RAGE Signaling Pathway Pubmed: 31858421 |
| Journal of Clinical Medicine | Damage-Associated Molecular Patterns and Th-Cell-Related Cytokines Released after Progressive Effort Pubmed: 32210109 |
| Journal of Immunology Research | Dendritic Cells Loaded with Heat Shock-Conditioned Ovarian Epithelial Carcinoma Cell Lysates Elicit T Cell-Dependent Antitumor Immune Responses In Vitro Pubmed: 31886313 |
| urologic oncology | A novel diagnostic tool for the detection of bladder cancer: Measurement of urinary high mobility group box-1 Pubmed: 32312640 |
| International Journal of Environmental Research and Public Health | Marathon Run-induced Changes in the Erythropoietin-Erythroferrone-Hepcidin Axis are Iron Dependent Pubmed: 32316587 |
| VETERINARY MICROBIOLOGY | Upregulation of HMGB1 Secretion in Lungs of Pigs Infected by Highly Pathogenic Porcine Reproductive and Respiratory Syndrome Virus Pubmed: 33221069 |
| Lab Invest | Extracellular cold-inducible RNA-binding protein regulates neutrophil extracellular trap formation and tissue damage in acute pancreatitis Pubmed: 32709888 |
| American Journal of Translational Research | Inhibition of calpain alleviates coxsackievirus B3-induced myocarditis through suppressing the canonical NLRP3 inflammasome/caspase-1-mediated and … Pubmed: 32509190 |
| STEM CELL REVIEWS AND REPORTS | A Novel Evidence That Mannan Binding Lectin (MBL) Pathway of Complement Cascade Activation is Involved in Homing and Engraftment of Hematopoietic Stem … Pubmed: 32406006 |
| Translational Stroke Research | Glycyrrhizin Prevents Hemorrhagic Transformation and Improves Neurological Outcome in Ischemic Stroke with Delayed Thrombolysis Through Targeting … |
| stem cells international | Hypoxic Wharton's Jelly Stem Cell Conditioned Medium Induces Immunogenic Cell Death in Lymphoma Cells |
| Frontiers in Cell and Developmental Biology | Aberrant Expression of High Mobility Group Box Protein 1 in the Idiopathic Inflammatory Myopathies |
| Naja sumatrana venom cytotoxin, sumaCTX exhibits concentration-dependent cytotoxicity via caspase-activated mitochondrial-mediated apoptosis without … | |
| Journal of Burn Care & Research | Umbilical cord mesenchymal stem cells (hUCMSCs) for inflammatory regulation after excision and grafting of severe burn wounds in rats 33313794 |
| Cell Death & Disease | DAMPs released by pyroptotic cells as major contributors and therapeutic targets for CAR-T-related toxicities 33504767 |
| Cells | Insights into P-Glycoprotein Inhibitors: New Inducers of Immunogenic Cell Death 32331368 |
| Infect Immun | A non-lethal murine flame burn model leads to a transient reduction in host defenses and enhanced susceptibility to lethal Pseudomonas aeruginosa infection 34152806 |
| Inhaled [D-Ala2]-Dynorphin 1-6 Prevents Hyperacetylation and Release of High Mobility Group Box 1 in a Mouse Model of Acute Lung Injury 34616852 | |
| Mol Cell Biochem | Autophagy-associated HMGB-1 as a novel potential circulating non-invasive diagnostic marker for detection of Urothelial Carcinoma of Bladder 34796446 |
| World J Gastroenterol | Calycosin attenuates severe acute pancreatitis-associated acute lung injury by curtailing high mobility group box 1-induced inflammation 34908806 |
| Endocr J | Clinical significance of high mobility group box 1/toll-like receptor 4 in obese diabetic patients 34657898 |
| Research in Veterinary Science | Choline or CDP-choline restores hypotension and improves myocardial and respiratory functions in dogs with experimentally–Induced endotoxic shock 34715589 |
| Sci Rep | Intracellular translocation of HMGB1 is important for Zika virus replication in Huh7 cells Pubmed:35058496 |
| ORL J Otorhinolaryngol Relat Spec | High Mobility Group Box-1 Protein and Interleukin 33 Expression in Allergic Rhinitis Pubmed:34979505 |
| J Exp Clin Cancer Res | SKP2 drives the sensitivity to neddylation inhibitors and cisplatin in malignant pleural mesothelioma Pubmed:35197103 |
| Am J Physiol Gastrointest Liver Physiol | Abnormal intestinal milieu in post-traumatic stress disorder is not impacted by treatment that improves symptoms Pubmed:35638693 |
| Journal of the South African Veterinary Association | Circulating markers of endothelial activation in canine parvoviral enteritis |
| Reseach square | The antiviral action of resveratrol against Zika virus through the regulation of interferon responses by HMGB1 |